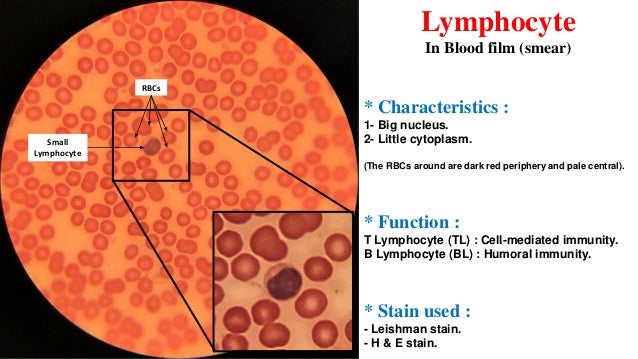

Blood Cells Histology Histology Images Of Blood Cells By Pathpedia.Com: Pathology E-Atlas
If you are searching about Je suis 'alia aqilah, et vous? =): Histology Slide - Microscope under you've came to the right web. We have 15 Pics about Je suis 'alia aqilah, et vous? =): Histology Slide - Microscope under like Histology images of Blood cells by PathPedia.com: Pathology e-Atlas, Histology Drawings: Peripheral Blood and also Vertebrate Histology Exam 2 Flashcards | Easy Notecards. Read more:
Je Suis 'alia Aqilah, Et Vous? =): Histology Slide - Microscope Under

blood microscope under lymphocytes slide film smear human vous alia suis je aqilah et leishman stain
Histology Slides

blood
Blood Histology - Blood - Histology Slide
histology blood slide album
Blood Histology

blood histology slideshare
ANAT2511 Circulatory System - Embryology
histology vein blood vessel vena cava muscle smooth tissue tunica artery cell veins intima arteries system connective valves embryology subendothelial
Histology Images Of Blood Cells By PathPedia.com: Pathology E-Atlas
blood cells histology cell pathpedia morphology monocyte atlas pathology
Gastrointestinal Tract - Pancreas Histology - Embryology
pancreas histology slide gland tract embryology duct exocrine islet endocrine file git liver salivary gastrointestinal frog development glands chicken adult
Bone Marrow. Blood. Cardiovascular System | Veterinary Histology

histology marrow veterinary ulpgc
Histology (histology Of Blood)
histology
Vertebrate Histology Exam 2 Flashcards | Easy Notecards

vertebrate histology bone types exam easynotecards
Thalassemia Laboratory Findings - Wikidoc
thalassemia findings smear blood laboratory cell wikidoc variations
Medulloblastoma In Childhood: New Biological Advances - The Lancet
medulloblastoma histological gr2
Webpathology.com: A Collection Of Surgical Pathology Images

hemangioma capillary lobular pathology nose webpathology nose2
Histology Drawings: Peripheral Blood

blood cells histology peripheral eosin hematoxylin drawings
Blood Histology ID Game

histology blood game
Histology images of blood cells by pathpedia.com: pathology e-atlas. Webpathology.com: a collection of surgical pathology images. Blood histology
0 Response to "Blood Cells Histology Histology Images Of Blood Cells By Pathpedia.Com: Pathology E-Atlas"
Post a Comment